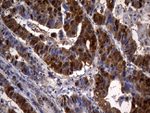
CSE1L Antibody in Immunohistochemistry (Paraffin) (IHC (P))

Search
OriGene
CSE1L Monoclonal Antibody (OTI4G1), TrueMAB™
{{$productOrderCtrl.translations['antibody.pdp.commerceCard.promotion.promotions']}}
{{$productOrderCtrl.translations['antibody.pdp.commerceCard.promotion.viewpromo']}}
{{$productOrderCtrl.translations['antibody.pdp.commerceCard.promotion.promocode']}}: {{promo.promoCode}} {{promo.promoTitle}} {{promo.promoDescription}}. {{$productOrderCtrl.translations['antibody.pdp.commerceCard.promotion.learnmore']}}
产品信息
TA812195
种属反应
宿主/亚型
分类
类型
克隆号
抗原
偶联物
形式
浓度
纯化类型
保存液
内含物
保存条件
运输条件
靶标信息
Proteins that carry a nuclear localization signal (NLS) are transported into the nucleus by the importin-alpha/beta heterodimer. Importin-alpha binds the NLS, while importin-beta mediates translocation through the nuclear pore complex. After translocation, RanGTP binds importin-beta and displaces importin-alpha. Importin-alpha must then be returned to the cytoplasm, leaving the NLS protein behind. The protein encoded by this gene binds strongly to NLS-free importin-alpha, and this binding is released in the cytoplasm by the combined action of RANBP1 and RANGAP1. In addition, the encoded protein may play a role both in apoptosis and in cell proliferation.
仅用于科研。不用于诊断过程。未经明确授权不得转售。
篇参考文献 (0)
生物信息学
蛋白别名: Cellular apoptosis susceptibility protein; Chromosome segregation 1-like protein; CSE1 chromosome segregation 1 like; CSE1 chromosome segregation 1-like; Exp2; Exportin-2; Importin-alpha re-exporter; MGC117283; MGC130036; MGC130037
基因别名: CAS; CSE1; CSE1L; XPO2
UniProt ID: (Human) P55060
Entrez Gene ID: (Human) 1434